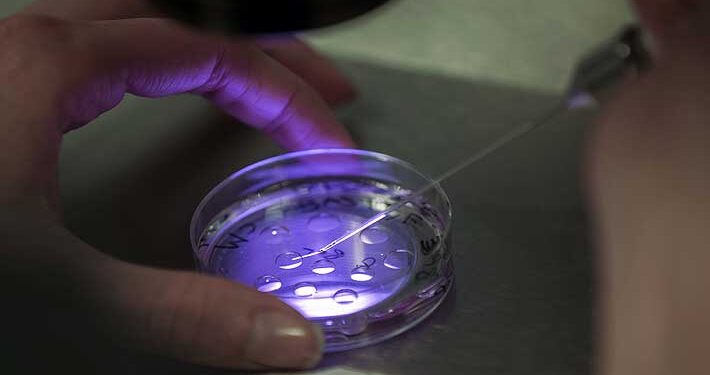
Nace en Reino Unido guagua con ADN de tres personas: evitaría heredar enfermedades incurables

Una guagua fecundada con ADN de tres personas nació en el Reino Unido, después de que los médicos utilizaran un innovador procedimiento con el objetivo de evitar que los niños hereden enfermedades incurables, publica este miércoles el periódico británico «The Guardian».
La técnica, conocida como tratamiento de donación mitocondrial (MDT, por sus siglas en inglés), utiliza tejido de los óvulos de mujeres donantes sanas para crear embriones en Fecundación In Vitro (FIV) libres de mutaciones dañinas que portan sus madres y que es probable que se las transmitan a sus hijos.
Debido a que los embriones combinan el esperma y el óvulo de los padres biológicos con diminutas estructuras similares a baterías llamadas mitocondrias del óvulo de la donante, la guagua resultante tiene ADN de la madre y el padre, además de una pequeña cantidad de material genético (alrededor de 37 genes) de la donante. Aunque hay ADN de una donante, el 99,8% del ADN del recién nacido procede de la madre y el padre, añade la información.
La investigación sobre MDT, que también se conoce como terapia de reemplazo mitocondrial (MRT), fue iniciada en el Reino Unido por médicos del Centro de Fertilidad de Newcastle (noreste inglés).
El proceso de Newcastle consta de varios pasos. Primero, el esperma del padre se usa para fecundar los óvulos de la madre afectada y una donante sana. Después se extrae el material genético nuclear del óvulo de la donante y se reemplaza con el del óvulo fertilizado de la pareja.
El óvulo resultante tiene un conjunto completo de cromosomas de ambos padres, pero lleva las mitocondrias sanas de la donante en lugar de las defectuosas de la madre.
Después se implanta en el útero. El trabajo tenía como objetivo ayudar a las mujeres con mitocondrias mutadas a tener bebés sin el riesgo de transmitir trastornos genéticos, según pudo saber «The Guardian».
Las personas heredan mitocondrias de su madre, por lo que las mutaciones dañinas pueden afectar a todos los hijos.
Para las mujeres afectadas, la concepción natural suele ser una incertidumbre, ya que algunas guaguas pueden nacer sanas porque heredan solo una pequeña proporción de las mitocondrias mutadas, pero otros pueden heredar mucho más y desarrollar enfermedades graves, progresivas y, a menudo, mortales. Aproximadamente uno de cada 6.000 niños se ve afectado por trastornos mitocondriales.
«The Guardian» dice que la Autoridad de Embriología y Fertilización Humana del Reino Unido (HFEA, siglas en inglés), regulador del sector, facilita la aprobación del procedimiento caso por caso, pero ya ha dado luz verde a por lo menos 30.
Los médicos de la clínica de Newcastle no han publicado los detalles de los nacimientos de su programa MDT, por temor a comprometer la confidencialidad del paciente. Sin embargo, el periódico dice que supo de este procedimiento a partir de una solicitud en virtud de las leyes sobre libertad de información.